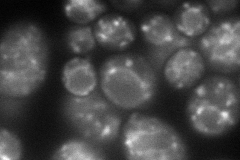
YGL104C
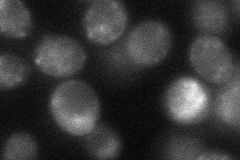
YGL104C

View description
Mitochondrial protein; mutation affects vacuolar protein sorting; putative transporter; member of the sugar porter family
Localization:
Intensity:
Fold change:
Significance:
-
C’ GFP library in SD

below threshold14.02 -
N' NOP1pr-GFP in SD
punctate,vacuole membrane133.457 -
N' TEF2pr-mCherry in SD

punctate,vacuole membrane152.751 -
N' NATIVEpr-GFP in SD

below threshold15.7023 -
N' TEF2pr-VC and Cyto-VN in SD
punctate31.5159 -
C’ GFP library in SD+DTT

cytosol14.171.01No -
C’ GFP library in SD+H2O2

cytosol13.790.98No -
C’ GFP library in Starvation Media

cytosol17.241.22No -
C’ GFP library on the background of Pup2-DaMP

below threshold -
C’ GFP library on the background of CCT mutant

below threshold14.57791.03896No
